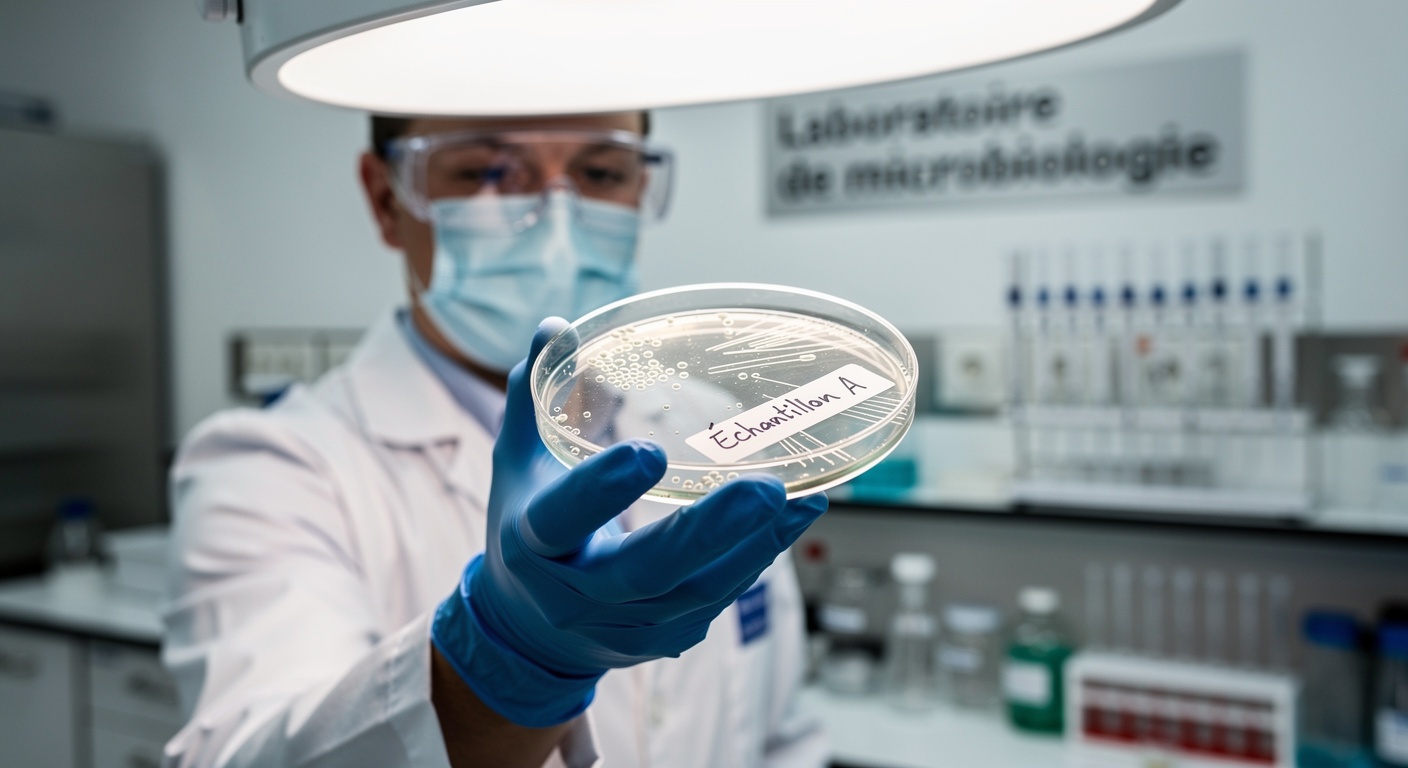

Un produit star de Costco de nouveau face à la justice

Le célèbre poulet rôti à 7,99 $ dollars de Costco fait de nouveau l’objet de poursuites judiciaires. Une nouvelle proposition d’action collective soutient que les clients ont surpayé pour un produit présenté comme sûr et digne de confiance. Au cœur de la plainte : l’enseigne n’aurait pas divulgué un problème présumé de contrôle de la salmonelle dans sa chaîne d’approvisionnement. Selon l’agence de presse Reuters, la plainte vise une usine de volaille du Nebraska et pointe du doigt les normes de sécurité du ministère de l’Agriculture américain (USDA).
Cette affaire n’est pas présentée comme un cas isolé d’intoxication alimentaire, mais plutôt comme une affaire de tromperie du consommateur. Pour des millions de foyers, le poulet rôti est un achat routinier, presque un réflexe. Ce dossier judiciaire interroge donc sur ce que les acheteurs sont en droit d’attendre au moment de passer en caisse. Quelle information un géant de la distribution doit-il partager avec ses clients ?
Le nom de Costco est d’ailleurs déjà associé à une autre affaire. Reuters rapporte qu’une action en justice distincte, en Californie, conteste l’utilisation du terme marketing « sans conservateurs ». La nouvelle plainte, elle, se concentre exclusivement sur le risque de salmonelle et le devoir d’information. Avec plus de 157 millions de poulets rôtis vendus dans le monde en 2025, selon les dires de Costco rapportés par Reuters, l’échelle du problème magnifie chaque question de valeur et de confiance. Pour l’heure, c’est aux tribunaux de déterminer quelles obligations d’information pèsent sur un simple poulet rôti.
Pour l’heure, c’est aux tribunaux de déterminer quelles obligations d’information pèsent sur un simple poulet rôti. Bien que cette affaire concerne principalement les États-Unis, elle pourrait également toucher le Canada, même si aucune donnée précise n’est encore disponible à ce sujet.
Au cœur de la plainte : une question de confiance et de prix

Déposée auprès du tribunal fédéral de Seattle, la nouvelle plainte est portée par Lisa Taylor, une habitante d’Affton, dans le Missouri. Elle explique acheter régulièrement un ou deux poulets rôtis par mois dans les entrepôts Costco près de Saint-Louis. Son argumentation se fonde sur un préjudice économique : elle estime que les consommateurs ont payé pour un produit présenté comme sûr, contrôlé et vendu honnêtement, alors que l’enseigne aurait omis de mentionner un risque de contamination par la salmonelle.
Lisa Taylor demande des dommages-intérêts compensatoires ainsi que des dommages-intérêts triplés. Sa démarche vise à couvrir toutes les personnes ayant acheté du poulet rôti de la marque Kirkland Signature, ainsi que certaines découpes de poulet cru, et ce, depuis le 1er janvier 2019. Elle allègue également que Costco a enfreint la loi sur la protection des consommateurs de l’État de Washington. La plainte suggère que la sécurité fait partie intégrante du contrat de vente. Les clients se seraient fiés à une promesse implicite que le poulet était propre à la consommation.
Reuters précise que Costco n’était pas disponible pour commenter, et que l’usine de volaille en question n’est pas désignée comme défenderesse. Le dossier s’appuie sur une étude liée à Farm Forward, une organisation à but non lucratif de défense des droits des animaux, et met en cause une usine de transformation située à Fremont, au Nebraska. Selon la plainte, cette usine échouerait « régulièrement » aux normes de sécurité de l’USDA. Plus de 9,8 % des poulets entiers et 15,4 % des découpes de poulet y auraient été testés positifs à la salmonelle. Pour les plaignants, ces chiffres sont la preuve d’un contrôle défaillant sur la durée.
L’argument clé : un manquement à l’obligation d’informer
La plainte utilise un langage direct, pensé pour un jury. On peut y lire cette phrase : « L’incapacité de Costco à contrôler la salmonelle dans sa chaîne d’approvisionnement en poulet n’est pas une simple formalité technique sans conséquence ». Les plaignants utilisent cette affirmation pour démontrer la matérialité du préjudice, un concept juridique qui interroge si une information, si elle avait été connue, aurait influencé la décision d’un consommateur raisonnable. Lisa Taylor soutient que le silence de l’entreprise peut être trompeur.
Elle affirme que, si elle avait eu toutes les informations, elle aurait payé moins cher pour le poulet, voire ne l’aurait pas acheté du tout. C’est ici que se jouera le combat principal. Costco devrait probablement rétorquer que la salmonelle est un danger connu dans la volaille et que son produit est vendu cuit, prêt à consommer. La plaignante, de son côté, insistera sur le fait que le litige porte sur des données de contrôle spécifiques et non divulguées. Les premières étapes de la procédure détermineront si cette omission est juridiquement attaquable.
Un autre enjeu sera la capacité de Lisa Taylor à représenter une large catégorie de consommateurs. Si l’affaire va de l’avant, la phase de « discovery » (communication des pièces) sera cruciale. Elle pourrait couvrir les registres de tests, les contrôles des fournisseurs et les discussions internes. Qu’est-ce que Costco savait et quand ? Le juge pourrait aussi se demander comment un acheteur aurait pu concrètement prendre connaissance de cette information en magasin. La réponse pourrait définir ce qui constitue une divulgation réaliste. Pour l’instant, il ne s’agit que d’allégations, et le tribunal décidera de la suite à donner.
Les normes USDA : un système de contrôle complexe
La plainte s’appuie sur un système technique utilisé par les régulateurs pour évaluer les usines de volaille. Le Service d’Inspection et de Sécurité Alimentaire (FSIS) fixe des normes de performance pour la salmonelle dans différentes catégories de volaille crue. Les inspecteurs prélèvent des échantillons sur une série définie, puis comparent les résultats à des seuils de référence. Le FSIS utilise une « approche par fenêtre glissante » pour l’échantillonnage, ce qui signifie que l’agence suit les résultats sur une période donnée, et non sur une seule journée.
Le FSIS classe également les établissements en fonction de leurs performances récentes. La catégorie 1 regroupe les meilleurs élèves, tandis que des catégories inférieures signalent des taux de positivité plus élevés. Ce système est conçu pour encourager l’amélioration continue des processus, et non pour garantir un poulet totalement exempt de bactéries. Néanmoins, il génère des indicateurs mesurables sur les contrôles d’une usine. Ces signaux sont importants pour les acheteurs gérant de vastes chaînes d’approvisionnement, et peuvent le devenir dans une affaire de consommation où un plaignant accuse un détaillant d’avoir caché une faiblesse connue.
La plainte, telle que décrite par Reuters, affirme que l’usine de Fremont, au Nebraska, a manqué à plusieurs reprises les objectifs de l’USDA, avec des taux de positivité présumés de plus de 9,8 % pour les poulets entiers et de 15,4 % pour les découpes. Le seuil de 9,8 % a été utilisé par le FSIS comme norme de performance pour les carcasses de poulets de chair dans ses publications. Un résultat positif lors d’un contrôle en usine ne signifie pas automatiquement qu’il y aura des malades. Le risque dépend de la cuisson, du stockage et des contaminations croisées. Costco pourrait d’ailleurs argumenter que la surveillance fédérale régit déjà ces contrôles et que son produit est vendu cuit.
Du risque en usine aux précautions à la maison

Un poulet rôti est vendu comme un aliment cuit, mais sa sécurité dépend aussi de ce qui se passe après l’achat. Une volaille cuite peut devenir risquée si elle est manipulée comme de la volaille crue. Une contamination croisée peut transférer des bactéries des mains ou des surfaces vers des aliments prêts à consommer. Le temps et la température sont également des facteurs critiques. Laissé sur un comptoir, le poulet peut traverser lentement la « zone de danger » de température, où les bactéries se multiplient rapidement.
Les agences sanitaires comme le FSIS recommandent de cuire le poulet entier à une température interne minimale de 165°F (environ 74°C), une règle qui s’applique aussi au réchauffage des restes. Pour les restes, il est conseillé de découper la viande et de la refroidir rapidement au réfrigérateur dans des récipients peu profonds. Concernant la salmonellose, le Centre pour le contrôle et la prévention des maladies (CDC) indique que les symptômes typiques sont la diarrhée, la fièvre et les crampes d’estomac, apparaissant généralement entre 6 heures et 6 jours après l’infection et durant de 4 à 7 jours.
Si la plupart des adultes en bonne santé se rétablissent sans traitement, le risque de complications (déshydratation sévère, infection sanguine) est plus élevé chez les jeunes enfants, les personnes âgées, les femmes enceintes et les personnes immunodéprimées. Ces réalités expliquent pourquoi les régulateurs surveillent la salmonelle de si près. La plainte de Costco n’exige pas de prouver que des clients sont tombés malades, mais que la confiance qu’ils ont achetée n’était pas pleinement méritée. En attendant l’issue judiciaire, les bonnes habitudes en cuisine restent la meilleure des protections.
Quelles suites en justice et quel impact pour les consommateurs ?

Les prochaines étapes judiciaires se concentreront probablement sur la certification de l’action collective. Pour cela, les plaignants devront prouver que la même omission a affecté tous les acheteurs de la même manière. Costco pourra soutenir que les clients ont acheté le poulet pour des raisons diverses, valorisant surtout le prix et la commodité plus que les indicateurs de performance d’une usine. L’argument du « produit d’appel » vendu à perte, mentionné par Reuters, complique d’ailleurs toute théorie de surpaiement.
Une autre action collective proposée à San Diego, également rapportée par Reuters, ajoute à la pression. Celle-ci allègue que Costco faisait la publicité de son poulet comme étant « sans conservateurs » alors qu’il contenait du carraghénane et du phosphate de sodium. De plus, l’affaire sur la salmonelle est liée à Farm Forward, dont la mission citée par Reuters est de « mettre fin à l’élevage industriel en changeant l’agriculture et les politiques ». Cela signale un agenda plus large derrière la plainte.
Si la classe est certifiée, l’affaire pourrait couvrir des millions d’achats depuis 2019. Dans le cas contraire, elle pourrait se réduire à la seule réclamation de Lisa Taylor. Quoi qu’il en soit, la pression pourrait pousser des détaillants à être plus transparents sur la sécurité. La loi de l’État de Washington permet au tribunal de tripler les dommages-intérêts, avec un plafond de 25 000 dollars pour ce montant majoré. Pour les consommateurs, la démarche pratique est simple : suivre les recommandations de cuisson et de stockage, et surveiller les avancées du dossier. Pour Costco, l’enjeu est clair : démontrer un contrôle rigoureux et communiquer avec des mots simples.
Créé par des humains, assisté par IA.










